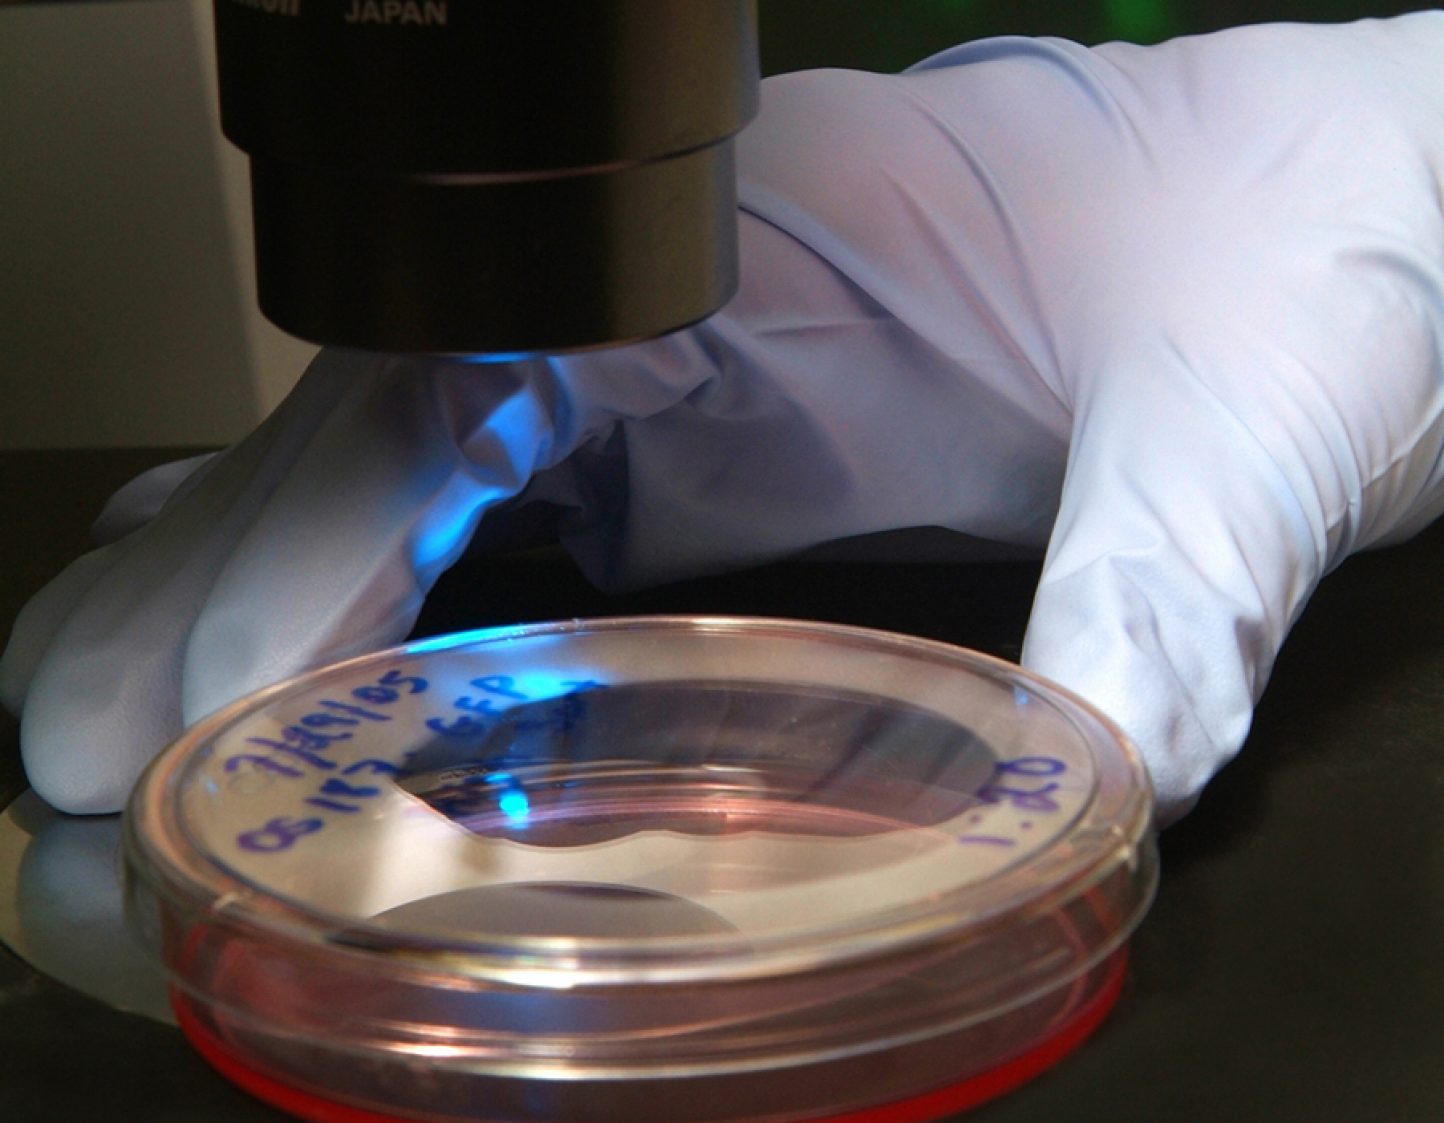

Visita a domicilio: De qué manera el tabaquismo afecta el aspecto
El tabaquismo causa envejecimiento prematuro y otros problemas estéticos
Tal vez haya escuchado que fumar cigarrillos causa cáncer de pulmón, boca, garganta, hígado, riñón, páncreas, colon y muchos más.
Tal vez también sepa que fumar puede causar enfermedades cardíacas, problemas de salud reproductiva, trastornos de la respiración, tales como bronquitis y enfisema, y otros problemas de salud. Pero ¿sabía que el cigarrillo afecta el aspecto de la persona?
Envejecimiento prematuro
Los fumadores tienen dos o tres veces más probabilidades de desarrollar arrugas faciales prematuras que los no fumadores. El tabaquismo hace que la piel pierda su elasticidad y humedad, le da una aspecto grisáceo y forma arrugas y surcos. Si bien esto es causado mayormente por la opresión de los vasos sanguíneos y los efectos secantes del humo del tabaco, se cree que los movimientos del acto de fumar—entrecerrar los ojos y apretar la boca—contribuyen a crear arrugas alrededor de los ojos y el labio superior. Debido a que los fumadores succionan cigarrillos repetidamente, es posible que también desarrollen mejillas huecas, dando lugar a una apariencia demacrada.
Esos efectos de envejecimiento prematuro a causa de los cigarrillos son aún más dramáticos que los resultantes de la exposición solar. Los efectos de envejecimiento del tabaquismo pueden hacerse evidentes incluso en un fumador de tan solo 20 a 30 años de edad. Para cuando el fumador tiene 40 años, puede tener tantas arrugas como un no fumador de 60.
Salud bucal deficiente
El tabaquismo puede hacer estragos en la boca de las personas. El cigarrillo es muy conocido por causar mal aliento y manchas en los dientes y las encías. El oscurecimiento de las encías por el humo del tabaco se llama “melanosis del fumador”. Otro efecto estético del tabaquismo es la “lengua de fumador”, caracterizada por manchas o parches blancos en la lengua. Un efecto similar es el “paladar de fumador”, también llamado estomatitis de la nicotina, un parche blanco grisáceo con protuberancias rojas en el paladar.
Debido a que el humo del cigarrillo debilita la capacidad del tejido de las encías de combatir las infecciones, los fumadores tienen más riesgo de sufrir periodontitis (inflamación de los tejidos próximos a los dientes), que puede causar inflamación de las encías y pérdida de dientes. Los fumadores no solo son más propensos a desarrollar periodontitis en primer lugar, también tienden a responder menos al tratamiento que los no fumadores.
Los fumadores que requieren implantes dentales tienen más probabilidades de tener complicaciones que los no fumadores. Y cuanto más fumen, mayores son las probabilidades de fracaso de los implantes.
Los problemas dentales no solo afectan el aspecto; también pueden afectar la capacidad de la persona de hablar y comer. Incluso cuando los problemas puedan solucionarse, requerirán muchos viajes al dentista.
Otras consecuencias
Además del envejecimiento prematuro y los problemas dentales, el cigarrillo se relaciona con varias afecciones que afectan la apariencia.
Psoriasis
En comparación con los no fumadores, los fumadores tienen aproximadamente el doble de probabilidades de desarrollar psoriasis, una afección crónica de la piel caracterizada por un sarpullido escamoso, desagradable e incómodo. Además, la psoriasis tiende a ser más grave en los fumadores que en los no fumadores.
Grasa en el abdomen
Los químicos del humo del cigarrillo hacen que el cuerpo almacene grasa en la cintura y el torso en lugar de las caderas. Como resultado, los fumadores a menudo tienen una mayor proporción de la cintura a la cadera que los no fumadores. Esto no solo causa flacidez en el abdomen, sino también un aumento del riesgo de diabetes y enfermedad cardíaca.
Acné
En comparación con los no fumadores, los fumadores tienen brotes de acné más frecuentes y graves, que luego tardan más en curarse.
Cabello dañado
El humo del cigarrillo afecta el cabello al reducir la circulación sanguínea y cambiar el ADN de los folículos pilosos. El resultado puede ser un aspecto opaco, decoloración y adelgazamiento del cabello, y canas prematuras.
Dedos manchados
Los fumadores tienden a tener amarillentos los dedos y las uñas de la mano con la que sostienen los cigarrillos.
Para muchos fumadores, el efecto del tabaquismo en su aspecto tiene un rol importante en la decisión de dejar de fumar. El hecho de dejar de fumar reduce la probabilidad de sufrir afecciones riesgosas para la vida, como el cáncer, y detiene la acumulación de daños al aspecto.
– E. Nielsen
Para más información, hable con su médico o llame a askMDAnderson al 877-632-6789. Para comunicarse con el Programa de tratamiento antitabáquico del MD Anderson, llame al 713-792-QUIT o al 866-245-0862. También puede visitar la página www.mdanderson.org o www.cancer.org/healthy/stayawayfromtobacco.
OncoLog, Noviembre-Diciembre 2016, Volumen 61, Números 11-12